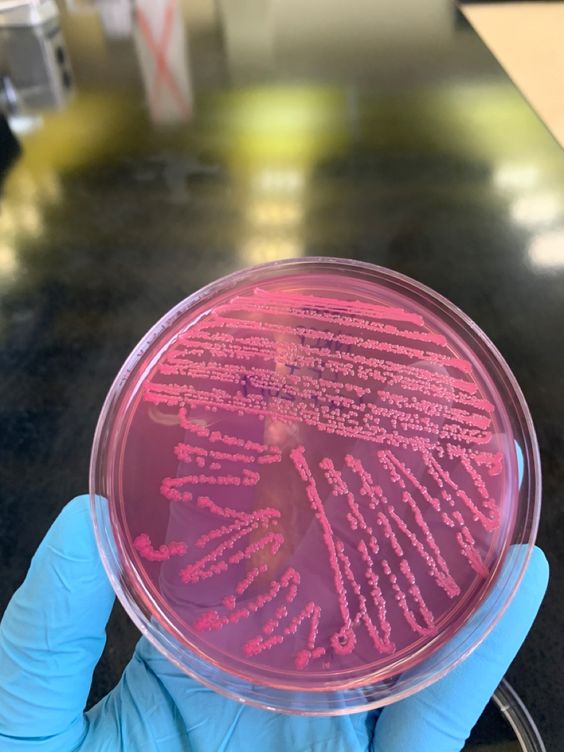

- Call Anytime: +254 704 150555
- info@biopassiondiagnostics.co.ke
About Us
Honesty is our moral compass. Integrity is in our DNA.
At Biopassion Diagnostics, we are loyal, enthusiastic and integral in all our dealings with our customers and with each other; therefore we uphold honesty and integrity above all else.
We believe our passion for surpassing expectations by putting the patient/clients first in everything we do and commitment to providing high quality, utmost accurate and timely medical laboratory services is one of the key reasons in our diagnostic excellence and reliability.
Services
Expect Nothing But The Best
From Biopassion Diagnostics
Get every single answers there if you want
-
What services does Biopassion Diagnostics offer?Biopassion Diagnostics provides a range of diagnostic services, including but not limited to genetic testing, molecular diagnostics, and personalized healthcare solutions. Our services are designed to cater to the diverse needs of individuals seeking insights into their health and well-being.
-
How can I schedule a diagnostic test with Biopassion?Scheduling a diagnostic test with Biopassion Diagnostics is easy. Simply visit our website or contact our customer service. You can choose from our list of available tests, book an appointment, and receive detailed instructions on the process. We strive to make the testing experience convenient and accessible.
-
Is my personal information kept confidential during the testing process?At Biopassion Diagnostics, we prioritize the confidentiality and security of your personal information. We adhere to strict privacy protocols and comply with all relevant data protection regulations. Your data is handled with the utmost care, and only authorized personnel involved in the testing process have access to the information.
-
How long does it take to receive test results?The turnaround time for test results may vary depending on the type of diagnostic test. Biopassion Diagnostics is committed to delivering accurate and timely results. Once your sample is received and processed, we strive to provide you with comprehensive reports promptly. You can check the estimated turnaround time for your specific test when scheduling your appointment.
Certified and experienced teams
Our staff have extensive knowledge and experience in their respective areas of service. They work in rigorous quality assurance programs to assure the highest quality of care for our patients.
Our highly trained medical laboratory experts are passionate about delivering healthcare of the highest quality to clients and are excited to be members of Biopassion Diagnostics. We collaborate with your personal physician and other experienced healthcare professionals, working toward the singular goal of patient satisfaction by ensuring detailed, accurate diagnoses and optimal treatment plans. Our team ensure your privacy at all stages of your treatment, including confidential transmission and distribution of reports.
Our advanced technologies and skilled department members ensures that you will remain as comfortable as possible during your medical care procedure in professionally managed environment.
In addition to offering state-of-the-art laboratory facilities to ensure reliable and accurate services, our staff strive to provide you with immediate appointments and to keep your wait between appointments to a minimum.


